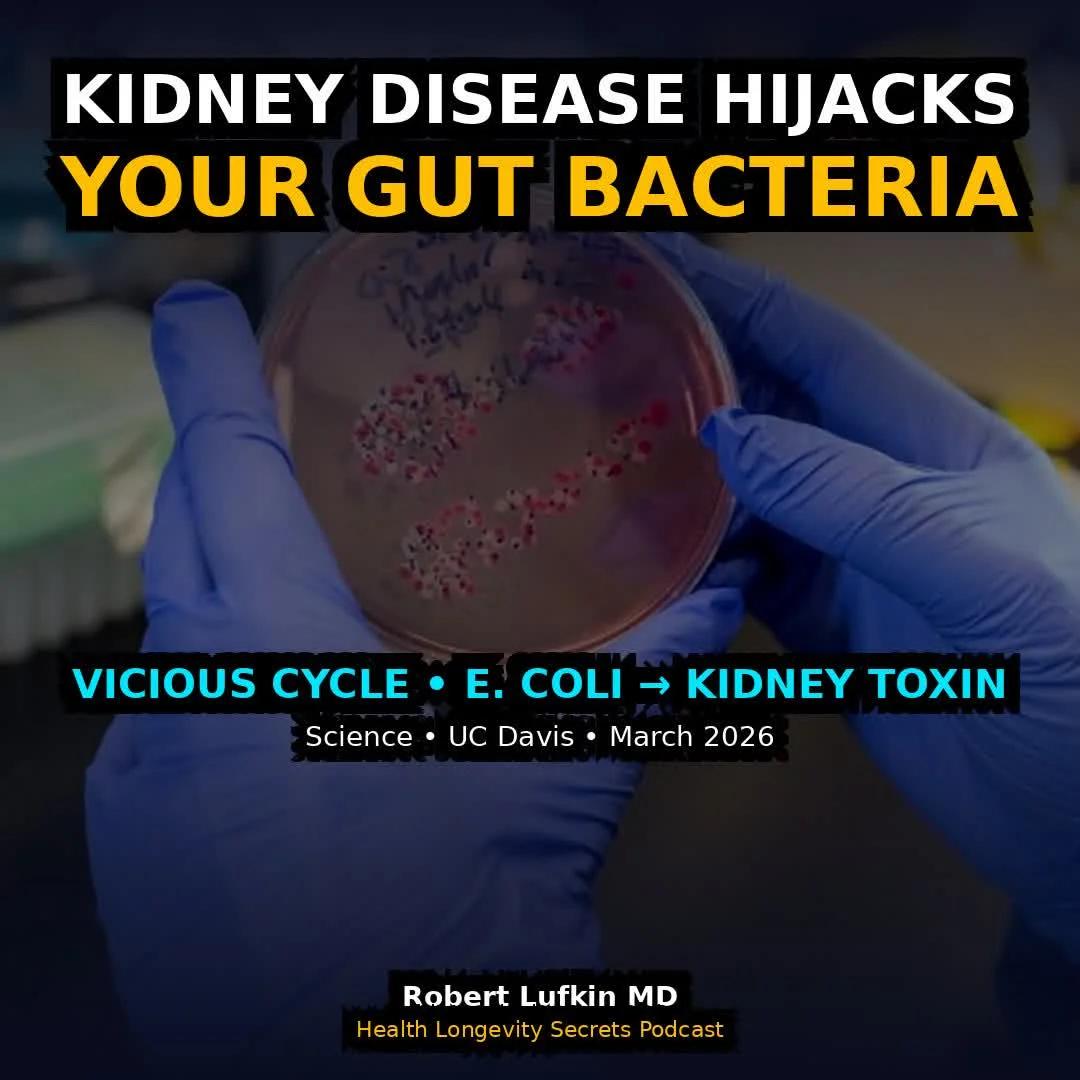
Kidney Disease Hijacks Gut Microbiome, Accelerating Decline

AI Matches Dermatologists in Melanoma Diagnosis, Study Shows
How good is AI for diagnosing melanoma? A systematic review of 11 studies, 2500 patients, finds accuracy and performance comparable to 50 dermatologists, with promise for broad use requiring further validation @JAMADerm This is important with the big shortage of dermatologists and importance of making the diagnosis https://t.co/0OWWZTNmN8

Self‑care for Moms Needs Support, Not Guilt
I’ll admit that I used to say “I’ll never let myself go” and now I realize that I didn’t know what I didn’t know. Can motherhood result in not taking care of yourself? For sure, but is it intentional? Hardly. Taking...

Thank Mentors by Becoming One Yourself
The best way to thank a mentor? Become one. It’s that simple and that powerful

Kids' Best Investment: Time, Not Pokemon Packs
This dad spent $1,750 on Pokemon cards for his kid's 9th birthday. That's 10 shares of $NTDOY — the company that makes Pokemon. $1,750 invested at 10% growth for 9 years = $4,100. The cards will be in a shoebox by Christmas. Parents, wake...

Lead by Example; Critics Never Learn Discipline
Some learn to execute WHEN I do. Others never learn not to whine about their lack of discipline https://t.co/huHkUGJkkT

WIDGET Drops Chaotic Disco‑punk Single Ahead of April Album
WIDGET charge forward with "Dogs Don’t Lie," a punchy, chaotic disco-punk cut from 'Classy Hits Vol.2.' The debut album arrives April 24, bringing their dancefloor energy straight into focus. https://t.co/6wemXiTPSL

Engineered Immune Cells Target Refractory Myeloma, Broader Cancer Potential
Steady progress towards engineering immune cells in the body now for refractory myeloma , with major implications for many autoimmune diseases and cancers https://t.co/K3IksrCFlg https://t.co/1AQ5rLuH1g

Open Chest, Strengthen Upper Back for Better Posture
Comment “community” to join my group coaching 3 exercises to improve shoulder mobility, open your chest and strengthen your upper back If your shoulders are stiff and your upper back is weak, your body tends to fall forward. Opening your chest and building...

Exercise Raises Plaque Yet Cuts Heart Risk
Regular exercise reduces the likelihood of plaque accumulation in the arteries However, many long-term exercisers appear to have coronary artery calcification, indicating atherosclerosis progression The fascinating thing is that despite the higher plaque, those people still have lower rates of cardiovascular disease...

City‑Level Diplomacy Could Revitalize the Middle East
Tel Aviv’s government released a new video to welcome Iranian tourists. The Middle East would be in much better shape if cities were in charge: TLV, Beirut, Dubai, Tehran, Cairo… some of the coolest places on earth. https://t.co/Cy72JT0KZY

Doers Create Conditions; Dreamers Wait for Perfection
The difference between dreaming and doing: Dreamers wait for perfect conditions Doers create new conditions One is a fantasy One is a practice

Self‑love Unlocks Health, Wealth, and Lasting Partnership
Life becomes 1000X easier when you have: - a healthy body - money in the bank - a loving partnership BUT none of this is possible if you don’t have a loving relationship with yourself (first). It takes work to love & accept yourself...

Exploring BTS’s Favorite NYC Eatery in New Substack Feature
In tribute to the new BTS album, a visit to their favorite NYC restaurant will appear on Friday in my Substack, Robert Sietsema's New York. https://t.co/GzIfm1wxUP

Prioritize Longevity: Listen to Your Body Over Speed
I think as you get older you learn to listen to your body more. You realize the game is about longevity, not just finishing the next race. It’s an important skill that takes time to improve

10 Albums That Sound Like Debuts But
Think you know an artist’s debut album? From ‘Control’ to ‘Dookie,’ here are 10 albums that feel like first statements, but actually came later. https://t.co/hC42VIdpiM

Progress Means Both Food Freedom and Mental Balance
For one person, progress is saying no to the pizza and ice cream so they can hit their calories. For someone else, progress is saying yes to the pizza and ice cream without getting anxiety or feeling like a failure. Progress is...

Daily 50‑ton Meteor Rain,
That rock fell from space on Saturday, burst through roof & ceiling, bounced hard enough off the floor to hit the ceiling again, and finally rattled to a stop. It sure surpised the family - thankfully, no one was hurt....

Optimal Pre‑Game Meal for Energy, Recovery, Hydration
If I had to recommend ☝️ one meal the night before a game or training event for max energy this would be the meal: -Roasted spinach -Coconut H20 -2 Oz of salmon -3 Oz of flank steak -Mashed sweet potatoes -Mixed fruit cup of cherries,...

TikTok Hit “Chest Pain” Goes Platinum, Hits Mainstream
Malcolm Todd's "Chest Pain (I Love)" has been certified Platinum in the United States for selling 1 million copies, proving that his viral TikTok hit has officially crossed over into mainstream success. https://t.co/IEu7xmdYq6

Delta Ends VIP Airport Service For
Delta Suspends VIP Airport Help For Congress — But Lawmakers Still Don't Have To Fly Like You - View from the Wing https://t.co/qkUTxmKrpX

Tom Waits' Nighthawks: Wild Live Studio Revelations
Potato chips, a stripper, and the classified ads: explore the wild, "live" studio sessions behind Tom Waits’ 1975 classic 'Nighthawks at the Diner'. https://t.co/yixhdwGKFL

Free Getty Center Views and Its Unique Otis Tram
The Getty Center and areas around the 405 and Sepulveda Pass in LA. The Getty Center is a Museum/civic complex. It's free and has some nice city views from its hilltop location. If you are ever in LA, visiting here...

Managers Judged by Team Results, Not Personal Work
You are a manager now. Your hands-on contributions no longer matter. You are judged entirely by the output of others. THE HARSH REALITY:

Hard Work Precedes True Smart Work
Working smarter not harder is a beautiful lie. You will not know how to work smart until you've worked very hard for an irrationally long time.

Creator Economy Booms While Mental Health Crises Double
1 in 10 content creators report serious mental health struggles tied to their work. That’s double the national average. At the same time, the creator economy is worth hundreds of billions and growing fast. So what’s broken? In this episode of TEQ, I...

Your Habits, Not Hacks, Define Who You Become
Small daily deposits: -Effort -Exercise -Gratitude -Help someone -Protein rich breakfast -100 oz of H20 -7-8 hours of sleep -Positive attitude -Show up on time -3 Fruits & veggies -Learn something new -Set limits on phone & social media time You're a combination of your daily habits not quick hacks.

Higher Phenotypic Age Accelerates Cancer Survivors' Mortality Risk
The association between phenotypic age acceleration and the risk of all-cause and cancer mortality among cancer survivors: NHANES 1999–2018 "Our findings reveal a significant linear correlation between PhenoAgeAccel and both all-cause and cancer-specific mortality in cancer survivors." https://t.co/Rt7v8ECOB6

Focus on What You Control, Release the Rest
One of the most important lessons I’ve learned is to distinguish between what you can control and what you can’t. You’ll lead a much happier life if you’re able to focus your energy on the things you can influence — like...

Planet Money Book Available for Pre‑Order – Worth Reading
If you're interested in the Planet Money book, it's good stuff and it's pre-orderable here: https://t.co/1E5mB8pXiM

Dominic McLaughlin Debuts as Harry Potter, Fans Thrilled
HBO just dropped the first photo of Dominic McLaughlin as Harry Potter and the Wizarding World looks exactly like it should. The 2027 premiere cannot come soon enough. https://t.co/vDP8I04omc

Emerging Artists Release Music Wrong, Losing Everything
Most emerging artists are releasing music completely wrong. Here is exactly what they are getting wrong, and why it is costing them everything. https://t.co/1tHGaacLz7

Finishing Creative Work Defies the Universe’s Constant Flux
There’s something unnatural about finishing a creative project. Creativity involves being open to new ideas, and finishing requires closing yourself off from them. The universe is constantly in flux, so to finish something, you need to hold a bunch of...

Emotional Regulation: Key Leadership Skill for Small Trade Firms
Emotional Regulation as a #Leadership Capability in Trade-Led Small Businesses @ABPsychologists https://t.co/Zl6yDQdEmy #HCM #HRM #HumanResources #HRTech #CHRO #FutureofHR

Cellist Janel Leppin Shares Raw, Expansive
Honored by the laughs-tears-joys-fears that cellist JANEL LEPPIN shared in this interview which felt as broad as her music https://open.substack.com/pub/thefutureisourstomake/p/we-gotta-get-our-forces-together

Thousands of P-Values, only a Handful Are Real
1/ You ran 20,000 differential expression tests. 1,000 genes came back with p < 0.05. How many are real? Maybe 50. Maybe fewer. Most bioinformaticians learn p-values in stats class. Almost nobody learns why they break at scale. Let me explain: https://t.co/btC71ABX5N

Dominic Fike’s “3 Nights” Hits 3× Platinum
Dominic Fike's "3 Nights" has been certified 3x Platinum in the United States for selling 3 million copies, a massive achievement for the debut single that became a global hit reaching the top 10 in multiple countries. https://t.co/HVRvxGctJn

New Bodhisattva Elle Painting Debuts at James Barron Art
Our newest painting of our Bodhisattva Elle, by artist @veragirivi - ▫️▫️▫️▫️▫️❓ Shows at jamesbarronart

Resilience Is Holding On When Inside Screams to Quit
Resilience depends on one thing: hanging on when everything inside us screams to let go.

Human Touch Turns Book Gift Into Awe
AI can't do this. I found out recently a friend had not read Anne of Green Gables. She's a voracious reader and exudes "kindred spirit" all day. Time to remedy that. So instead of just ordering the book. I decided to gift her the...

Snail Mail Dismisses “Sad Girl” Label, Talks Surgery
"I don't feel like it really benefited anybody": Snail Mail on rejecting the "sad girl" genre, vocal surgery, and the Goo https://t.co/OHnnvHdjqB

Accountability Fuels Growth: Embrace Your Full Potential
Growth starts with accountability. ✨🤍 Be honest with yourself - are you living up to your fullest self? 🙏

Roscosmos Unveils First Image From Elektro‑L5 Satellite
Roskosmos published first image from the Elektro-L5 weather satellite which was launched in February. Full size version and context: https://t.co/XRGzszjsAK https://t.co/KYrEHQmwWr

Five Days of 40% Fat Leaves Performance Unchanged
Short-term higher fat intakes do not impair performance 🥑 This new study recruited 20 healthy adults to complete 2 x 5-day diets… 1️⃣ Higher fat diet (40% total energy) 2️⃣ Standard fat diet (30% total energy) Both diets were matched for total calories and...

Recovery Across Body, Mind, Spirit Drives True Performance
14 thoughts on recovery: 1. There are three types of recovery: physical recovery, mental recovery, and spiritual recovery. 2. You are either working or recovering on all three dimensions. There is no in between. 3. You can operationalize recovery on three dimensions: your...

Speed Reading Won’t Make Knowledge Stick Without Processing
I'm a neuroscientist who graduated top 1% in medical school. 3 reasons nothing you study actually sticks: Myth #1: 3x speed = 3x knowledge Your brain needs time to process new information - pause, explain it, question it.
Kidney Disease Hijacks Gut Microbiome, Accelerating Decline
As a medical school professor, this is one of the most terrifying feedback loops I've seen in medicine. UC Davis researchers just published in Science showing how chronic kidney disease hijacks gut bacteria to destroy your kidneys FASTER. The mechanism: 1. Damaged kidneys...

Fall Hiking in Southern Greenland: Pure Scenic Bliss
Still probably one of the most beautiful hikes I've ever done. Southern Greenland in fall.

ISS Captures Progress MS-33 Docking with Antenna Snag
Newly released images taken from the ISS of yesterday's docking with the Progress MS-33 cargo ship, with a stuck antenna clearly visible on the right of docking mechanism. More pics and context: https://t.co/GL29AvnJQ5 https://t.co/7idPQ8z9Ix

Sunrise over A380 Wing: Pure Sydney Bliss
ah.. that "Sunrise over the starboard wing of an @AirBus #A380 as you're coming into #Sydney" moment.. pure bliss.. https://t.co/gZ6ZxTzQAT

Clear Decision Authority, Not More People, Speeds Projects
I’ve seen teams try to “go faster” on a website rebuild by throwing more people at it. It rarely works. Speed usually comes from one boring thing. Decisions that get made on time. If you want a faster project, I’d look at these...